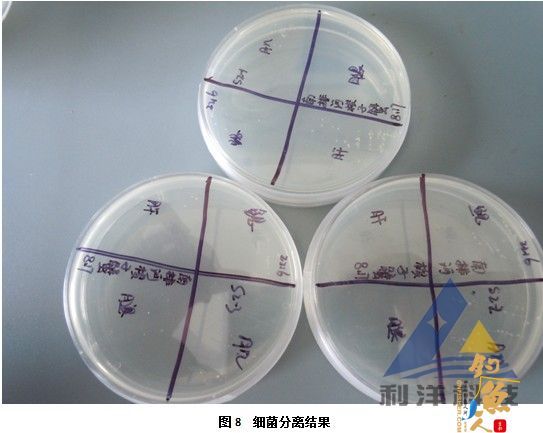
血卵涡鞭虫感染引起三疣梭子蟹死亡一例 全面组图

天津南排河一口三疣梭子蟹和日本对虾混养池塘,水面20亩,水深1.5m,4月底投放虾苗、蟹苗,先后投喂卤虫、兰蛤、冰鲜鱼。8月15日左右开始拉网卖蟹,但拉不出来螃蟹,而池边有大量爬边死蟹。
8月17日到池塘现场查看(图1),水体淡绿色,镜检以硅藻为主,盐度22‰,下午17:30用简易测试盒测水质, pH值8.5,氨氮0.2mg/L, 亚硝酸盐0.05mg/L。池边大量爬边死的梭子蟹,还有大量梭子蟹在池边缓慢爬动(图2)。病蟹为十期梭子蟹(图3、4),外观与正常蟹基本无差异,掂起来与同样大小的正常蟹相比明显要轻。
解剖见鳃部略呈黄色,肝胰腺萎缩严重,空肠空胃,肌肉萎缩、液化呈透明状,略显浅黄色,与正常蟹肌肉颜色差别不大(图5),剪断游泳足挤出淋巴液滴在载玻片上呈现乳白色。打开病蟹体腔时,可见液化状肌肉剧烈震动,鳃部压片可见大量纤毛虫、菌以及虫体(图6),肌肉压片以及步足淋巴液压片同样可见大量虫体(图7)。接种鳃、肝胰腺、步足肌肉、腿部肌肉进行细菌分离培养,取肌肉、鳃提取DNA做相关分子检测,取肝胰腺、鳃做病理组织切片观察。
结果:梭子蟹样品均分离出少量细菌(图8),但并无明显优势菌群;根据文献许文军(2007)设计的引物序列合成引物,进行PCR特异性扩增,得到约600bp的目的条带,回收后测序,与血卵涡鞭虫的序列相似性高达99%,图9中sample1为所采样品,sample2为对照;病理组织切片结果显示所取样品鳃丝外侧有纤毛虫,鳃小片内部有大量虫体(图10),肝胰腺腺管萎缩,有大量虫体充盈其中(图11),同样肌肉中虫体数量颇为可观,肌肉有液化、溶解、坏死现象(图12)。
分析:1、血卵涡鞭虫属植鞭动物门、腰鞭虫纲、Syndinida目、血卵涡鞭虫属,是海洋捕捞和海水养殖甲壳类的重要病原性寄生虫,主要寄生血腔、肝胰脏、肌肉等组织,造成甲壳类大量死亡。
2、本病例采集的样品镜检后能看到大量寄生原虫,发病梭子蟹的症状主要为肌肉液化,透明水样,步足关节膜处透明状,病理组织切片见肌肉纤维断裂、液化,并非资料中(许文军等,2006)描述的血卵涡鞭虫引起的肌肉浊白色牛奶状,步足关节膜处呈黄色或浊白色症状。而当地也发生一种养殖户称为“牙膏蟹”疾病,与资料中(许文军等,2006)描述症状相同,但初步诊断病原不是本病例中的血卵涡鞭虫,其具体病因还在进一步调查。
3、血卵涡鞭虫完整的生活史尚不清楚,确切的感染与传播途径可能因宿主和虫体种类不同而存在差异。一般认为通过水体和食物都能传播,健康蟹残食病蟹可能是重要的感染途径,对发病池塘中桡足类等浮游动物进行血卵涡鞭虫的PCR 检测, 也检出部分阳性结果,推测桡足类也可能是该寄生虫的中间宿主或直接宿主。据资料雌性个体的发病率高于雄性,在蜕壳、产卵和交配期尤其容易感染,而在盐度低于18的水体该病很少发生。
4、血卵涡鞭虫病没有有效的治疗方法,正确预防是控制该病的主要途径。选择体质健壮、无伤病、规格较大的种苗,经检疫和消毒后再放养,大量投喂鲜活饵料使水质、底质恶化也是血卵涡鞭虫容易感染的因素。发现疾病后,可及时采取措施控制病原的传播与扩散,病蟹应消毒深埋或销毁处理,以免进一步传染。(利洋技术部 杨慧英 南排河店 张杰 研究所 戚瑞荣提供 2013.06.27)

|